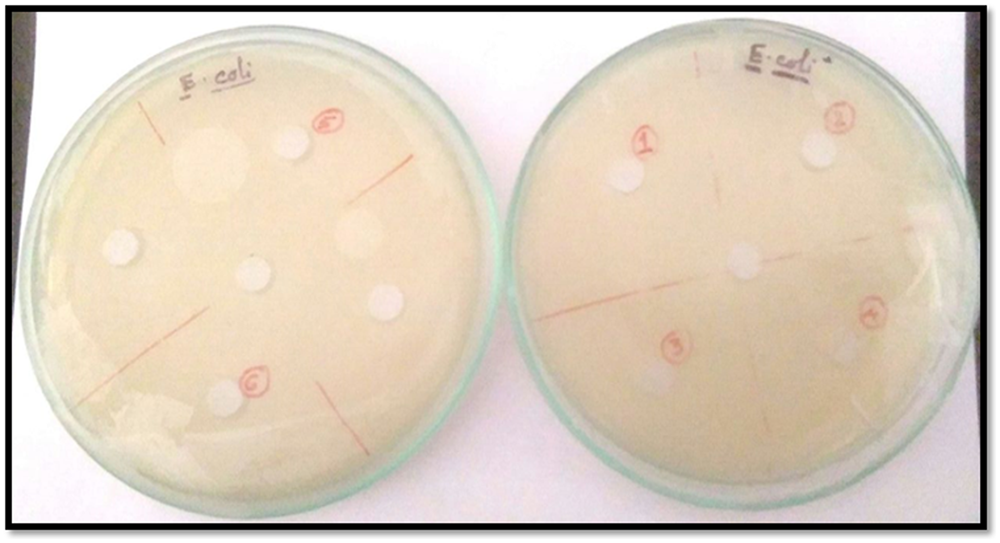
Figure 19

Figure 19
Antimicrobial activity analysis α-CD, β-CD on Gram-negative E. coli by Agar Cup method. No zone of inhibition is observed. Double distilled water is taken as the control. [Marker points (red) for the verified samples taken in the plates (1. SNP, 2. PEHB, 3. PEHA, 4. SNPA, 5. PEH, 6. SNPB) and Marker points (black) for the model organism taken in the plates].